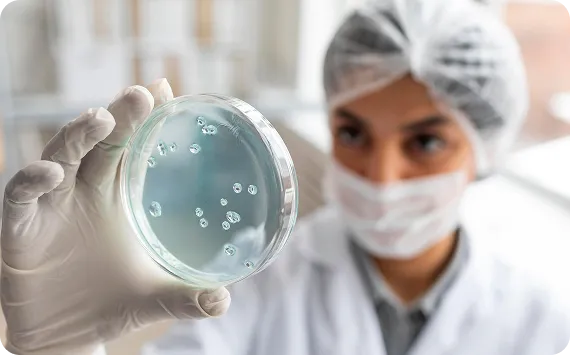

1- Line up all the Major offenders, and disrupt their activities the same way they have disrupted your health. Make it personal.
2- Stop the unnecessary use of over the counter pain medication and the Anti Acid products and the over use of Antibiotics. Only when you absolutely need them.
3- Stay away from Lectins and Glutens. We will show you how to cook some of those, if you insist on having some of them.
4- Replace all the major offenders with the major defenders: High quality fiber, Resistant starch, and polyphenol. These are the fuel and food of your great bacteria.
5- Enhance and speed up the road to recovery by using the correct, high quality, targeted supplements that are a must for speedy results.
A strong microbiome equals a strong immune system.



